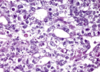
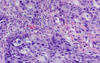

Gupta - Pathology Flashcards
(296 cards)
What do you see here?

- First-trimester chorionic villi
- Composed of delicate mesh of central stroma surrounded by two discrete layers of epithelium:
1. Outer layer of syncytiotrophoblast (group of cells; two arrows) and
2. Inner layer of cytotrophoblast (single cells; arrow) - Smaller, more vascular, less trophoblast thickness as the pregnancy progresses
What is this?

- Third-trimester chorionic villi
- Composed of stroma with:
1. Dense network of dilated capillaries
2. Surrounded by markedly thinned-out syncytiotrophoblast and cytotrophoblast - REMEMBER:
1. Syncytio: think groups of cells
2. Cyto: think single cells
What kind of growth restriction do fetal abnormalities cause? Specific causes?
- SYMMETRIC: all organ systems are similarly affected
- Caused by chromosomal disorders, congenital anomalies, and congenital infections:
1. TORCH group of infections; usually transplacental -
a. Toxoplasmosis: usually 1st infection is the one that causes most problems (i.e., if mom has never been exposed before)
b. Rubella
c. Cytomegalovirus (CMV)
d. Herpesvirus (HSV)
2. Other viruses/bacteria, i.e., syphilis bacteria, listeria - NOTE: wear gloves if working in the garden while pregnant

What kind of growth restriction do placental abnormalities cause? Specific causes?
- ASYMMETRIC: spares brain (via a down-regulation of growth in latter 1/2 of gestation)
- Uteroplacental insufficiency may result from:
1. Umbilical-placental vascular anomalies (like single umbilical artery, abnormal cord insertion, placental hemangioma),
2. Placental abruption (detachment from uterus),
3. Placenta previa (covers opening of mom’s cervix),
4. Placental thrombosis and infarction,
5. Placental infection, or
6. Multiple gestations - NOTE: 3rd trimester loss is usually placental insufficiency
What kind of maternal abnormalities may cause fetal growth restriction?
- Those that result in DEC placental blood flow
1. Vascular diseases, like preeclampsia (toxemia of pregnancy) and
2. Chronic hypertension, are often the underlying cause - Usually some kind of vascular issue
What is spontaneous abortion? Causes?
- MISCARRIAGE: pregnancy loss <20 wks gestation
1. Fetal chrom anomalies: approx 50% of early abortuses
2. Maternal endocrine factors: luteal-phase defect, poorly controlled diabetes, other uncorrected endocrine disorders
3. Physical defects of uterus: submucosal leiomyomas, uterine polyps or malformations, may prevent or disrupt implantation
4. Systemic disorders affecting maternal vasculature: antiphospholipid Ab syndrome, coagulopathies, and HTN - NOTE: families get very upset about losing the fetus early, but this may be a “good” thing in many cases, i.e., due to a chromosome abnormality
When might ascending infections cause pregnancy loss?
- 2nd trimester
- Losses due to fetal and maternal anatomic abnormalities are also common in the 2nd trimester
What is this?

- Listeria: necrotizing intervillositis
-
Non-pasteurized cheeses and milk (KNOW THIS: may get a question about it) -> if the infection is bad enough, you may lose this pregnancy
1. Outbreaks in some places where people eat a lot of unpasteurized cheeses (also cold cuts)
What is going on here?

- Chorioamnionitis: maternal inflammatory response to intervillositis
- These are ascending infections, so often maternal inflammatory response (not placenta)
- Lots of inflammation: would also call this deciduitis (this is acute inflammation -> mostly polys)
- NOTE: layers here are amnion, chorion, decidua
What do you see here?

- Necrotizing funisitis: due to Candida, in this case
- Punctate, 1-2mm yellow-white nodules on the cord (Candida always looks the same)
- Generally track the coils of the cord vessels, and are noted initially along the perimeter of the umbilical vein (3 vessels: 2 aa, 1 vein)
- Established, or long-standing infections can cause tissue necrosis and accumulation of cellular debris (necrotizing funisitis)
- False knot in the cord here
What is this?

- Subamniotic microabscesses typical of Candida funisitis
- Very characteristic, but not specific for this organism
- Inflammation of the umbilical vessels (vasculitis) and cord substance (funisitis) occurs in response to the infection -> FETAL INFLAMMATORY RESPONSE
-
Wharton jelly: supporting substance in umbilical cord that looks like jelly grossly, but pink ground substance in this micro
1. Right side of the image is the outside of the umbilical cord
2. Artery on the left
What is this?

- Candida pseudohyphae with GMS silver stain in subamniotic foci
- Funisitis: umbilical cord with subamniotic microabscesses
- Inflammation located at the periphery or surface of the umbilical cord may be the primary pattern seen (peripheral funisitis)
- Fungal ball
What is phlebitis?
- Inflammation of the umbilical vein
- Can be seen separately from arteritis (inflammation of umbilical arteries)
What do you see here?

- Chronic villitis with CMV: likes vascular endothelium
- Nuclear AND cytoplasmic inclusions (herpes would only have nuclear inclusions)
- This case is SEVERE
What is this?

Chronic villitis with CMV
What is going on here?

- Parvovirus B19: erythema infectiosum (slap cheek)
- Viral inclusions in early erythroid precursors
- Bone marrow sample b/c don’t see nucleated red cells in peripheral system, unless something is wrong
What do you see here? Arrow?

- Parvovirus B19: erythema infectiosum
- Erythroblasts in lumen of capillary vessels of the placental villi show eosinophilic nuclear inclusions
An image of fetal membranes are shown. Iron stain was negative. The histologic finding indicates what?

A. Meconium was present in the amnionic cavity
B. Placental abruption
C. Congestive heart failure in the fetus
D. Acute chorioamnionitis
A. Meconium was present in the amniotic cavity
- Passage of meconium in utero due to bowel peristalsis and relaxation of anal sphincter -> may be indicative of fetal distress
- Meconium components diffuse into placenta and cord, leading to vasoconstriction + hypoperfusion; damage to fetus INC with length of exposure
- Neonates are at risk for meconium aspiration
- Meconium is unlikely in fetuses <30 wks gestation
-
Meconiophages: brown-green pigment, usually right below amnion, in the chorion
1. Top a little bit of amnion layer (low, cuboidal epithelium), then chorion, then decidua (big, fluffy, pink cells)
2. Hemosiderin-laden macros would have been positive for iron
What is twin-twin transfusion syndrome?
- A complication of monochorionic twin pregnancy
- Monochorionic twin placentas have vascular anastomoses that connect twin circulations, and in some cases these connections include one or more INC blood flow to one twin at expense of the 2nd, one twin will be underperfused, while the second will be fluid overloaded
- If severe, this may result in the death of one or both fetuses
- Most twins Di/Di, so this syndrome is RARE

What may have happened here?

- Twin-twin transfusion syndrome: a complication of monochorionic twin pregnancy
- Monochorionic twin placentas have vascular anastomoses that connect twin circulations, and in some cases these connections include one or more INC blood flow to one twin at expense of the 2nd, one twin will be underperfused, while the second will be fluid overloaded
- If severe, this may result in the death of one or both fetuses

What is the most common site of ectopic pregnancy? Causes?

- Approximately 90% of cases in extrauterine fallopian tube
- Can rupture (gross image on front of this card), leading to hemoperitoneum, which is dangerous
- 50% are idiopathic, and the other 50% may be infection, leiomyoma causing obstruction, etc.
- Takes a “villous” to prove ectopic pregnancy; chorionic villi float on water

Describe each of these abnormalities of placental implantation (A-D).

- Fertilized ovum normally implants in uterine fundus
A. Normal placenta
B. Placenta previa: very low lying placenta, or one that covers the os -> severe hemorrhage can result, w/cervical dilation and passage of the baby through the birth canal
C. Placenta accreta: no formation of a normal decidual plate -> chorionic villi extend into myometrium, and placenta can’t separate normally post-delivery; severe hemorrhage
D. Abruptio placenta: premature separation of placenta prior to delivery, with formation of a retroplacental blood clot between decidua and uterine wall -> blood supply of O2 and nutrients to fetus compromised to greater degree with INC size of the abruption
What do you see here?

- Placenta accreta: NO formation of normal decidual plate -> chorionic villi extend into myometrium, and placenta can’t separate normally post-delivery, leading to severe hemorrhage
- Microscopically, the placental villi interdigitate directly with the uterine myometrium, without an intervening decidual plate
How is placental invasion into the myometrium classified (chart)?